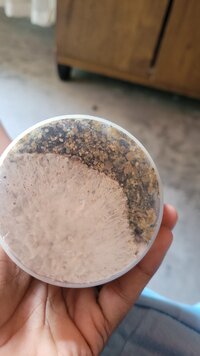

- Raças
- Penis envy 7 plus
- Inoculação
- 03/02/2025
- Inoculação via
- Cultura liquida
- Assepsia (Inoculação)
- Ar livre com velas
- Terrário
- Caixa organizadora
- Técnicas
- Pftek
- Substratos
- Farinha de arroz integral
Vermiculita
Farinha de milho
Comecei o cultivo dia 03/02/25, decidi começar com a cultura liquida por parecer ser a mais fácil de lidar, logo que chegou já quis fazer tudo o quanto antes e foi aí que cometi um erro atrás do outro.
Da seringa que eu adquiri tentei multiplicar e o resto inocular o substrato. Como eu disse estava com muita pressa e não tinha tudo que era necessário, então improvisei, bati milho de pipoca no liquidificador até virar um pó (quebrou o copo do liquidificador) então decidi bater flocão de cuzcuz, usei a proporção do pftek e preparei tudo com muita pressa, já comecei errando preparando com milho e flocão, mas os erros não param por aí.
Usei uma panela de pressão para esterilizar deixei 40 minutos no total contando antes mesmo de pegar pressão outro erro... Esperei mais ou menos 2 horas para esfriar, mas obviamente não foi o suficiente, ainda estava quente por fora então por dentro devia estar ainda mais quente, inoculei no chão do meu quarto sem lavar e também não tinha álcool 70%, usei somente velas e fogo na seringa, então se sair algo disso é um milagre.
Com farinha de milho:


Inoculei 5ml, mais tarde descobri aqui pela comunidade que foi um exagero, eu pensei que quanto mais melhor, erro meu.
Três dias depois compre arroz integral e álcool, não consegui achar o 70% sem ser em gel, comprei outro, mas que dizia matar 99,9% das bactérias.
Preparei novamente o substrato, deixei de 50 minutos a 1 hora na pressão e depois deixei esfriar por umas 6 horas fora da panela.
Inoculei em uma cadeira no meu quarto que eu havia lavado um dia antes com bastante qboa (água sanitária) deixei a cadeira com qboa em cima dela até a hora da inoculação, coloquei uma camisa no rosto como se fosse uma máscara e inoculei três substratos com a cultura que eu tinha multiplicado, apliquei 10ml dividido em 3 pontos em cada pote de 500ml, acho que exagerei.
1°




2°



3°




Todos estão com esse excesso de umidade, alguém pode me informar se vai prejudicar o cultivo ou se tem alguma contaminação? É o meu primeiro cultivo e não sei se está indo tudo bem, mesmo com tantos erros.
O pote com farinha de milho parou de colonizar a mais de uma semana, separei ele dos outro pra ver se saia do lugar, mas nada de evoluir.





Provavelmente não dá pra ver pela foto, mas na parede do pote está com uma úmidade turva. Estou pensando em separar a parte que já colonizou para tentar salvar.
Já os outros três potes terminaram a colonização ontem (ter. 04/03) vou aniversariar sexta-feira.




Estou com dúvida se faço dunk ou não é necessário, parecem estar bem úmidos, mas já vi cultivadores dizerem que além de hidratar, o dunk serve pra dar um choque no micelio e agilizar a frutificação.
Dia 07/08 fiz dunk



No dia seguinte montei o terrario, deixei eles de lado, mas depois resolvi colocar em pé já que estava pinando só de um lado

Pinou dia 12/03

Coloquei os bolos na vertical



Da seringa que eu adquiri tentei multiplicar e o resto inocular o substrato. Como eu disse estava com muita pressa e não tinha tudo que era necessário, então improvisei, bati milho de pipoca no liquidificador até virar um pó (quebrou o copo do liquidificador) então decidi bater flocão de cuzcuz, usei a proporção do pftek e preparei tudo com muita pressa, já comecei errando preparando com milho e flocão, mas os erros não param por aí.
Usei uma panela de pressão para esterilizar deixei 40 minutos no total contando antes mesmo de pegar pressão outro erro... Esperei mais ou menos 2 horas para esfriar, mas obviamente não foi o suficiente, ainda estava quente por fora então por dentro devia estar ainda mais quente, inoculei no chão do meu quarto sem lavar e também não tinha álcool 70%, usei somente velas e fogo na seringa, então se sair algo disso é um milagre.
Com farinha de milho:


Inoculei 5ml, mais tarde descobri aqui pela comunidade que foi um exagero, eu pensei que quanto mais melhor, erro meu.
Três dias depois compre arroz integral e álcool, não consegui achar o 70% sem ser em gel, comprei outro, mas que dizia matar 99,9% das bactérias.
Preparei novamente o substrato, deixei de 50 minutos a 1 hora na pressão e depois deixei esfriar por umas 6 horas fora da panela.
Inoculei em uma cadeira no meu quarto que eu havia lavado um dia antes com bastante qboa (água sanitária) deixei a cadeira com qboa em cima dela até a hora da inoculação, coloquei uma camisa no rosto como se fosse uma máscara e inoculei três substratos com a cultura que eu tinha multiplicado, apliquei 10ml dividido em 3 pontos em cada pote de 500ml, acho que exagerei.
1°




2°



3°




Todos estão com esse excesso de umidade, alguém pode me informar se vai prejudicar o cultivo ou se tem alguma contaminação? É o meu primeiro cultivo e não sei se está indo tudo bem, mesmo com tantos erros.
O pote com farinha de milho parou de colonizar a mais de uma semana, separei ele dos outro pra ver se saia do lugar, mas nada de evoluir.

Provavelmente não dá pra ver pela foto, mas na parede do pote está com uma úmidade turva. Estou pensando em separar a parte que já colonizou para tentar salvar.
Já os outros três potes terminaram a colonização ontem (ter. 04/03) vou aniversariar sexta-feira.




Estou com dúvida se faço dunk ou não é necessário, parecem estar bem úmidos, mas já vi cultivadores dizerem que além de hidratar, o dunk serve pra dar um choque no micelio e agilizar a frutificação.
Dia 07/08 fiz dunk



No dia seguinte montei o terrario, deixei eles de lado, mas depois resolvi colocar em pé já que estava pinando só de um lado

Pinou dia 12/03

Coloquei os bolos na vertical



Anexos
Última edição: